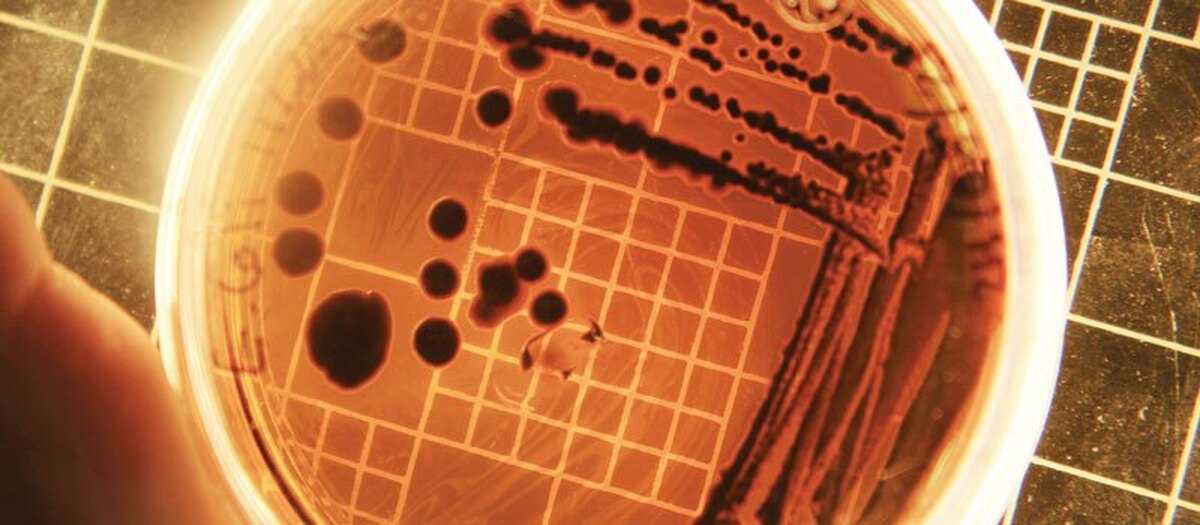

داستان سیاهزخم، روایتی است از تلاقی علم، قدرت و تاریکترین وجوه طبیعت انسانی اما چگونه یک باکتری راهش را از آزمایشگاههای علمی به میدان جنگ بازد کرد؟ باکتری که قرار بود راهی برای نجات انسان باشد و خودش جان بسیاری از از انسانها را گرفت.
یک بیماری «پشمریسان»
سیاهزخم در گذشته با نامهایی چون «بیماری پشمریسان» یا «بیماری باربر پوست» شناخته میشد. این بیماری اغلب کارگرانی را درگیر میکرد که با پشم یا پوست حیوانات سروکار داشتند. ضایعات پوستی دایرهایشکل با مرکز سیاهرنگ، نشانه بارز آن بود؛ نشانهای که نام بیماری را نیز شکل داد؛ چرا که واژه «آنتراکس» در یونانی به معنای «زغال» است.
عامل بیماری، باکتری Bacillus anthracis است؛ میکروبی که میتواند به شکل غیرفعال و بسیار مقاوم به نام «اسپور» در خاک باقی بماند. این اسپورها از طریق علوفه وارد بدن دامها میشوند و پس از فعال شدن، سمومی ترشح میکنند که عامل اصلی علائم شدید و گاه مرگبار بیماری است.
راههای ابتلا و خطرناکترین سناریو
سیاهزخم میتواند از سه مسیر وارد بدن انسان شود: از راه پوست، دستگاه گوارش یا سیستم تنفسی. نوع پوستی معمولا با ضایعات موضعی همراه است و در صورت درمان، مرگومیر کمی دارد. نوع گوارشی با علائمی مانند تهوع، اسهال و درد شکم بروز میکند اما خطرناکترین شکل، نوع تنفسی است؛ جایی که استنشاق اسپورها میتواند به نارسایی تنفسی و مرگ منجر شود. با وجود این، سیاهزخم از انسان به انسان منتقل نمیشود و همین ویژگی، آن را به گزینهای جذاب برای کاربردهای نظامی تبدیل کرده است.
نقطه عطف علم؛ رابرت کخ و اثبات عامل بیماری
در سال ۱۸۷۶، رابرت کخ، دانشمند آلمانی، برای نخستین بار موفق شد عامل سیاهزخم را بهطور علمی شناسایی کند. او با پرورش باکتری در محیط کشت و انتقال آن به حیوانات سالم، نشان داد که این میکروب علت مستقیم بیماری است. این آزمایشها به تدوین «اصول کخ» انجامید؛ چهار معیار بنیادین که هنوز هم پایه تشخیص ارتباط میان میکروب و بیماری بهشمار میروند. کشف کخ، نقطه عطفی در تاریخ میکروبشناسی بود.
پاستور و تولد واکسن
چند سال بعد، لویی پاستور، دانشمند فرانسوی، گامی فراتر از دانشمند آلمانی برداشت. او با تضعیف باکتری سیاهزخم و تزریق آن به گوسفندان، موفق شد نخستین واکسن مؤثر علیه این بیماری را تولید کند. آزمایش تاریخی او در سال ۱۸۸۱ نشان داد که علم میتواند در برابر یکی از مرگبارترین بیماریهای شناختهشده، سدی کارآمد ایجاد کند اما این تنها روی روشن ماجرا بود؛ چراکه این پژوهشها و کشفهای شگفت علمی توسط سودجویانی به بیراهه رفت.
سیاهزخم در خدمت جنگ!
در قرن بیستم، سیاهزخم وارد مرحلهای تاریکتر شد.درجریان جنگ جهانی اول، آلمان تلاش کرد ازاین باکتری برای آلوده کردن دامها و اسبهای سوارهنظام دشمن استفاده کند.چند دهه بعد، ژاپن در دوران اشغال منچوری،سیاهزخم و دیگر عوامل بیولوژیک را روی اسرای جنگی آزمایش و حتی با هواپیما بر فراز شهرهای چین منتشر کرداوج این برنامهها در جنگ جهانی دوم رقم خورد. بریتانیا با همکاری آمریکا و کانادا، «عملیات گیاهخوار» را برای آزمایش سیاهزخم بهعنوان سلاح آغاز کرد. آزمایشها در جزیره گرونارد اسکاتلند انجام شد؛ جایی که آلودگی آنچنان شدید بود که جزیره تا ۴۵ سال غیرقابل سکونت باقی ماند. هرچند این سلاح هرگز در میدان نبرد استفاده نشد، اما پیامدهای زیستمحیطی آن برای دههها باقی ماند.
سوانح مرگبار؛ وقتی کنترل از دست میرود
حتی در دوران صلح، سیاهزخم قربانی گرفته است. درسال۱۹۷۹،نشت اتفاقی اسپورهاازیک مرکز نظامی در سوردلوفسک شوروی، جان دستکم ۶۸ نفر را گرفت. سالها بعد، مشخص شد که یک خطای ساده انسانی، مانند تعویضنشدن فیلتر هوا، میتواند فاجعهای انسانی را رقم بزند.برای افکار عمومی، سیاهزخم بیش از هرچیز با حملات پستی سال ۲۰۰۱ در آمریکا گره خورده است. نامههایی حاوی اسپورهای این باکتری به رسانهها و سناتورها ارسال شد و موجی از وحشت بهراه انداخت. در این حملات، پنج نفر جان باختند. تحقیقات گسترده افبیآی در نهایت یک پژوهشگر دفاع زیستی ارتش آمریکا را بهعنوان عامل معرفی کرد؛ پروندهای که نشان داد تهدید، الزاما از بیرون مرزها نمیآید.
مقاوم، خاموش و ماندگار
یکی از ویژگیهای نگرانکننده سیاهزخم، دوام شگفتانگیز اسپورهای آن است. این اسپورها میتوانند دههها در خاک، یخ و حتی لاشههای منجمد باقی بمانند. شیوع سال ۲۰۱۶ در شبهجزیره یامال روسیه، که پس از ذوب یک لاشه قدیمی رخ داد، یادآور این واقعیت تلخ بود که گذشته میتواند ناگهان به حال بازگردد.
سیاهزخم نماد دوگانهای خطرناک است: از یکسو، پیشرفتهای علمی که جان میلیونها نفر را نجات دادهاند و از سوی دیگر، سوءاستفاده از همان دانش برای تخریب و کشتار. باکتریها بهخودی خود بیطرفند، اما انسانها نه. تاریخ سیاهزخم نشان میدهد که مرز میان درمان و تهدید، باریکتر از آن است که تصور میکنیم؛ مرزی که عبور از آن، تنها به یک تصمیم اخلاقی بستگی دارد.